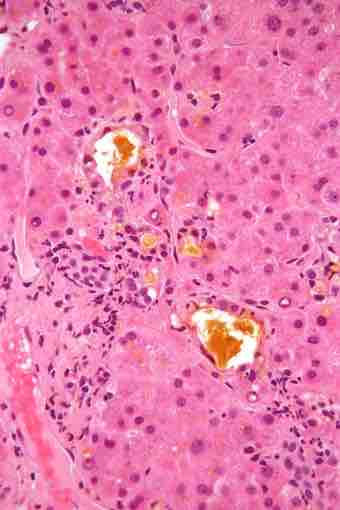
Cholestasis 2 high mag

Digestive System > The Liver
The Liver

- The Liver
- Anatomy of the Liver
- Histology of the Liver
- Blood Supply to the Liver
- Liver Function
- Bile
Free to share, print, and make copies or changes. Get yours at www.boundless.com.
https://www.boundless.com/physiology/
https://www.boundless.com/physiology/
Digestive System > The Liver
Bile
Micrograph of bile (yellow material) in a liver biopsy.
Free to share, print, and make copies or changes. Get yours at www.boundless.com.
https://www.boundless.com/physiology/
https://www.boundless.com/physiology/
Related PowerPoint Templates
Overview of the Digestive System
PowerPoint template · 11 slides
Nervous System of the Digestive System
PowerPoint template · 9 slides
The Peritoneum
PowerPoint template · 10 slides
The Alimentary Canal
PowerPoint template · 0 slides
Layers of the Alimentary Canal
PowerPoint template · 14 slides
The Stomach
PowerPoint template · 12 slides
The Gallbladder
PowerPoint template · 0 slides
The Pancreas
PowerPoint template · 0 slides
The Small Intestine
PowerPoint template · 11 slides
The Large Intestine
PowerPoint template · 14 slides
Chemical Digestion
PowerPoint template · 12 slides
Absorption
PowerPoint template · 10 slides
Phases of Digestion
PowerPoint template · 10 slides